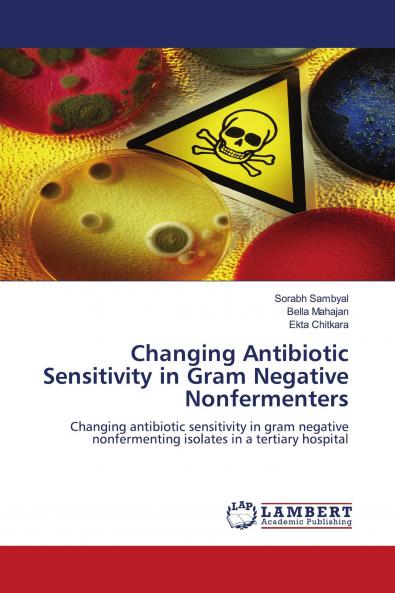
Changing Antibiotic Sensitivity in Gram Negative Nonfermenters

English
Paperback
₹3654
₹3847
5.02% OFF
(All inclusive*)
Delivery Options
Please enter pincode to check delivery time.
*COD & Shipping Charges may apply on certain items.
Review final details at checkout.
Looking to place a bulk order? SUBMIT DETAILS
Delivery Options
Please enter pincode to check delivery time.
*COD & Shipping Charges may apply on certain items.
Review final details at checkout.
About The Book
Description
Author
Nonfermenting Gram negative bacteria are the potential microbes that are distributed widely in nature and have been isolated from soil water and from medical devices as well as from clinical specimens. The Nonfermentative Gram negative bacteria are primarily opportunistic. The (NFGNB) Nonfermentative Gram negative bacteria are known to account for about 15% of all bacterial isolates from a clinical microbiology laboratory. Antibiotic resistance among bacteria is becoming more and more serious problem throughout the world. It is said that evolution of bacteria towards resistance to antimicrobial drugs including multidrug resistance is unavoidable because it represents a particular aspect of the general evolution of bacteria that is un-stoppable. Antibiotic resistance emerges commonly when patients are treated with empiric antimicrobial drugs.
Details
ISBN 13
9786204747132
Publication Date
-02-06-2022
Pages
-68
Weight
-101 grams
Dimensions
-150x220x4.09 mm